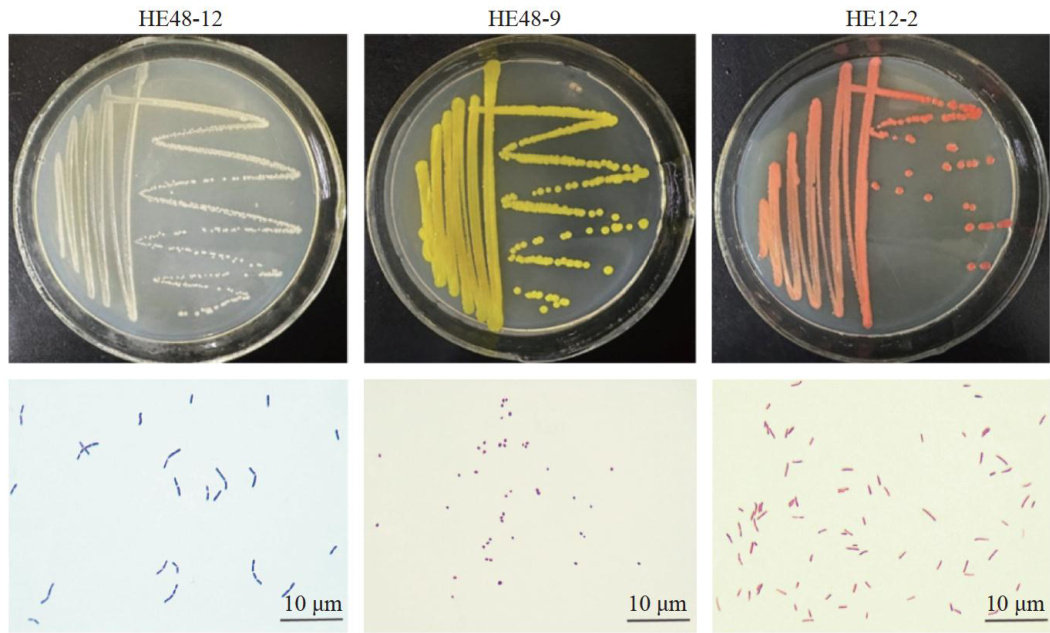

马铃薯叶内生细菌对马铃薯块茎蛾取食胁迫的响应
打开文本图片集
中图分类号:S435.32 文献标志码:A 文章编号:1004-390X(2025)06-0008-1
Abstract: [Purpose] To investigate changes in the structure diversity endophytic bacterial communities within potato leaves following feeding stress by potato tuber moth (Phthorimaea operculella), providing theoretical support for research on potato insect resistance mechanisms the exploration beneficial plant endophytic bacteria resources.[Methods] Potato variety Hezuo 88 was used as indoor potted material. Third-instar larvae the potato tuber moth were introduced to potato seedlings to induce feeding stress at12, 24, 36, 48h ,setting as treatments, with no-stress control. Isolation culture high-throughput sequencing techniques were used to analyze changes in the community composition diversity endophytic bacteria in potato leaves. [Results] Potato tuber moth feeding stress altered the endophytic bacterial community composition in potato leaves. After12,24,36, 48h feeding stress, the relative abundance Firmicutes increased by 21.43% (204号 8.70% , 27.27% , 58.53% , respectively; the relative abundance Actinobacteria increased by 5.00% 2.50% , 10.00% , 3.70% ,respectively; the relative abundance Proteobacteria decreased by 66.67% 28.03% 55.56% , 60.05% ,respectively. The relative abundance Staphylococcus increased by 14.57% , 113.87% , 51.44% , 175.36% ,respectively; while that Bacillus decreased by 8.73% , 57.10% , 40.56% 86.65% ,respectively; Paracoccus waspresent in all time points the control group,while in the treatment group, it appeared only at 48h ,showing an 89.75% reduction compared to the control. PICRUSt1 functional prediction results indicated that after potato tuber moth feeding stress, the metabolic functions endophytic bacteria in potato leaves showed high-abundance enrichment, primarily involving amino acid carbohydrate metabolism. [Conclusion]Potato tuber moth feeding stress alters the composition relative abundance the endophytic bacterial community in potato leaves, enhancing the enrichment metabolic functions within the leaves.
Keywords: potato; potato tuber moth (Phthorimaea operculella); stress response; endophytic bacteria; culturable bacteria; high-throughput sequencing
内生菌与宿主植物在共同进化过程中形成了良好的互惠共生关系,二者之间的互作可提高植物的抗虫性[1-2]。(剩余16143字)